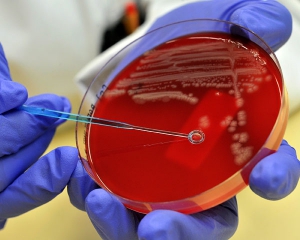

Спалах гострого інфекційного захворювання, викликаного кишкової бактерією E.coli, зафіксована серед дітей у французькому Ліллі. Шестеро хворих госпіталізовано. Причиною зараження стали рубані біфштекси. Фахівці, однак, не пов'язують цей спалах з інфекцією, що охопила Німеччину.
Хворим французьким дітям від двох до восьми років. Вони живуть в різних містах регіону Нор-Па-де-Кале. Всі постраждалі їли рубані біфштекси фірми Steaks Country, куплені у великій мережі супермаркетів Lidl, після чого у них почалася кривава діарея, пише Newsru.
У четвер вранці трьох дітей підключили до апарату гемодіалізу. "Їх стан серйозний, однак не викликає побоювань", - заявили журналістам медики.
За словами експертів міністерства, виявлена у Франції бактерія "ніяк не пов'язана з інфекцією, яка спалахнула в Німеччині" і забрала життя 38 людей в Європі. Найближчим часом будуть проведені всі необхідні дослідження, щоб зрозуміти характер інфекції і повністю виключити її зв'язок з німецькою E.coli.
Компанія-виробник біфштексів в ніч на четвер відкликала всю партію своєї продукції, яка, як передбачається, є джерелом небезпечної інфекції, передає РИА "Новости".
Крім того, влада рекомендує громадянам смажити рубане м'ясо без його розморожування, оскільки бактерія гине вже при температурі в 65 градусів за Цельсієм. Чиновники також попросили населення негайно звертатися по допомогу до лікарів у разі появи симптомів або порушення роботи шлунково-кишкового тракту протягом 10 днів після вживання в їжу біфштексів цієї марки.
Коментарі
2